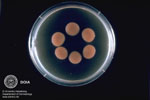
Cryptococcus neoformans

|
Systemische Mykosen
Systemische Mykosen sind insgesamt selten, meist findet primär eine pulmonale Infektion mit allmählicher Ausbreitung auf die Haut statt. Systemische Pilzinfektionen erfordern meist eine interdisziplinäre Therapie und Diagnostik.
Häufig kommen folgende Mykosen als Ursache systemischer Pilzinfektionen vor:
Cryptococcus neoformans
|
|
|
 Aspergillus fumigatus
|
|
|
- Candidiasis (Erreger Candida albicans)
- Aspergillose (Erreger Aspergillus niger)
- Kryptokokkose (Erreger Cryptococcus neoformans)
- Histoplasmose
- Coccidioidomykose
- Blastomykose
Candidiasis und Aspergillose treten meist als opportunistische Infektion bei immungeschwächten Personen auf. Kryptokokkose, Histoplasmose, Coccidioidomykose und Blastomykose werden von obligat pathogenen Pilzen ausgelöst, d.h. auch immunkompetente Menschen erkranken daran.
In Europa ist eine Infektion mit Histoplasmose, Coccidioidomykose und Blastomykose extrem selten (Reiseanamnese).
|